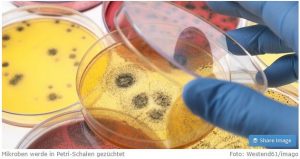

Bakterien als Klimaschützer taz: In Zeiten der globalen Angst vor einem Virus hat man es als Mikrobe nicht leicht. Doch ForscherInnen der US-Universität Purdue haben in der Arktis Bakterien gefunden, … Bakterien als Klimaschützer weiterlesen
0 Kommentare